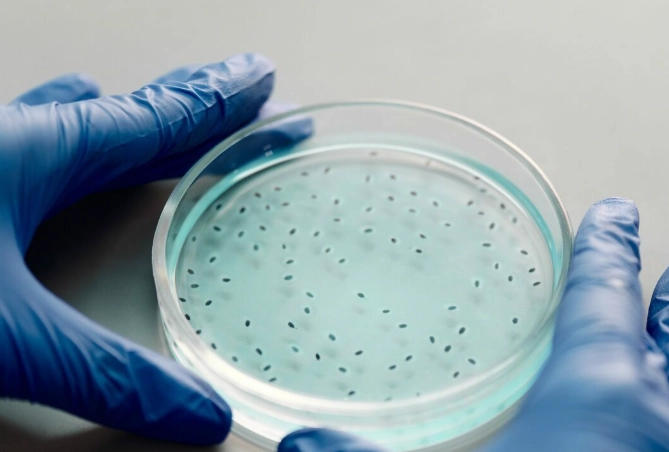
probiotic for bad breath

Quick Guide to Fresh Breath
- Forget the Gut for a Second: We're Talking Oral Probiotics
- The Top Contenders: Probiotic Strains That Actually Work for Bad Breath
- Head-to-Head: Comparing the Top Strains for Halitosis
- How to Choose a Probiotic for Halitosis: Beyond the Strain Name
- How to Use Oral Probiotics for Maximum Effect
- Common Questions (The Stuff You're Really Wondering)
- The Bigger Picture: Probiotics Are One Tool, Not the Whole Toolkit
Let's be honest, mouthwash and mints are a band-aid. You know it, I know it. That faint worry in the back of your mind after a conversation, the constant checking... it's exhausting. If you're searching for "what probiotic strain is best for halitosis," you're already on the smarter path. You're looking to fix the problem, not just mask it. And you're right to look at probiotics.
But the supplement aisle is a jungle. Blurry labels, huge claims, and a dozen different bacterial names that sound like science fiction. It's enough to make you grab the familiar mint gum and call it a day.
Don't.
The answer to fresher breath isn't about killing everything in your mouth with alcohol. It's about balance. It's about seeding your mouth with the right kind of good bacteria that crowd out the smell-producing troublemakers. It's a gardening project for your gums and tongue. And just like gardening, you need the right seeds.
The Core Idea: Halitosis (chronic bad breath) often stems from an imbalance in your oral microbiome. Harmful bacteria on the tongue and gums break down proteins, releasing foul-smelling volatile sulfur compounds (VSCs). The right probiotics can help restore balance by directly competing with these odor-causing bugs.
Forget the Gut for a Second: We're Talking Oral Probiotics
Most people think of probiotics for their stomach. And while gut health matters, for bad breath, we need soldiers that report for duty in the mouth. They need to be able to stick to your oral surfaces—your tongue, your cheeks, your gumline—and set up shop. Not all bacteria can do that.
So, when we ask "what probiotic strain is best for halitosis?", we're specifically looking for strains that are native or highly adaptable to the oral environment, with proven research behind them for reducing those smelly sulfur compounds.
I remember when I first dug into this, I assumed all probiotics were created equal. A few billion CFUs of anything labeled "probiotic" should work, right? Wrong. It's like assuming any seed will grow a tomato. You might get a plant, but it won't be the tomato you wanted.
The Top Contenders: Probiotic Strains That Actually Work for Bad Breath
Based on clinical studies and the mechanisms of action, a few stars have emerged. These are the strains you should be looking for on the label.
The Heavy Hitter: Streptococcus salivarius (especially K12 and M18)
If there's a reigning champion for oral probiotics, it's Streptococcus salivarius. This isn't the bad strep throat bacteria. S. salivarius is a dominant, friendly resident in a healthy mouth. Two specific variants have been studied extensively:
- S. salivarius K12: This is my top pick, and here's why. It's a powerhouse at producing something called BLIS (Bacteriocin-Like Inhibitory Substances). Think of BLIS as targeted antibiotics that only kill the bad guys. K12 specifically targets bacteria like Streptococcus pyogenes, but its presence and the compounds it creates seem to create an overall healthier environment that's hostile to VSC-producers. Studies have shown it can significantly reduce volatile sulfur compound levels, which are the direct cause of that rotten egg smell. It's also heavily researched for throat and ear health, which is a nice bonus.
- S. salivarius M18: Another superstar. While K12 is a great generalist, M18 has a special talent: it produces enzymes (dextranase and urease) that help break down dental plaque and neutralize acidic conditions in the mouth. This makes it particularly good for overall oral hygiene, which is directly linked to fresher breath. A cleaner mouth is a less smelly mouth.
Sounds almost too good, right? But the mechanism is straightforward. These strains colonize the tongue and throat, taking up space and resources so the odor-causing bacteria can't get a foothold. They're the friendly neighborhood watch.
The Strong Support: Lactobacillus Strains
You know these from yogurt. While they are more famous for gut work, specific Lactobacillus strains have shown promise for oral health and, by extension, halitosis.
- Lactobacillus reuteri: This one is well-researched for its anti-inflammatory properties. Gum inflammation (gingivitis) is a major contributor to bad breath because it creates pockets where bacteria hide and thrive. By promoting healthier gums, L. reuteri indirectly tackles a root cause of halitosis. Some studies have shown it can reduce plaque and gingivitis scores.
- Lactobacillus salivarius: Don't confuse it with Streptococcus salivarius! This is a different genus, but it's also a common resident in a healthy mouth. Research indicates it can inhibit the growth of pathogens like Porphyromonas gingivalis, a key player in gum disease and bad breath.
- Lactobacillus paracasei: Known to help reduce levels of cavity-causing Streptococcus mutans. While cavities themselves can cause odor, the broader effect is again about shifting the overall bacterial balance towards a less pathogenic community.
The thing about Lactobacillus strains is they might not colonize the mouth as permanently as S. salivarius. They're more like helpful visitors that need regular replenishment. But as part of a blend, they add valuable firepower.
The Niche Player: Weissella cibaria
This is a newer kid on the block, but the research is fascinating. Weissella cibaria seems to be exceptionally good at physically binding to and clumping together with the primary VSC-producing bacteria, like Fusobacterium nucleatum. It literally glues them together, preventing them from spreading and making it easier for them to be washed away by saliva. It's like throwing a net over the troublemakers. A study published in the Journal of Clinical Periodontology found it effectively reduced bad breath parameters.
A Quick Reality Check: No single strain is a magic bullet for 100% of people. Your oral microbiome is as unique as your fingerprint. The "best" probiotic strain for halitosis for you might be a combination that addresses your specific imbalance. Someone with more tongue coating issues might benefit massively from S. salivarius K12, while someone with underlying gum inflammation might see better results with a formula containing L. reuteri.
Head-to-Head: Comparing the Top Strains for Halitosis
Let's break this down visually. This table compares the key players in the "what probiotic strain is best for halitosis" debate.
| Probiotic Strain | Primary Mechanism for Fighting Halitosis | Clinical Evidence Support |
|---|---|---|
| Streptococcus salivarius K12 | Produces BLIS bacteriocins to inhibit pathogens; colonizes tongue/throat. | Strong. Multiple studies show reduction in VSCs and oral malodor. |
| Streptococcus salivarius M18 | Produces plaque-disrupting enzymes; promotes a healthier oral pH. | Strong. Shown to improve plaque indices and oral hygiene markers. |
| Lactobacillus reuteri | Reduces gum inflammation (gingivitis); modulates immune response. | Moderate to Strong. Good evidence for gingivitis reduction. |
| Lactobacillus salivarius | Inhibits growth of periodontal pathogens like P. gingivalis. | Moderate. Promising in-vitro and some clinical data. |
| Weissella cibaria | Aggregates and co-aggregates with VSC-producing bacteria, removing them. | Emerging but Promising. Specific studies on halitosis show positive effects. |
See the pattern? They all attack the problem from different angles. That's why the best products often contain a blend.
How to Choose a Probiotic for Halitosis: Beyond the Strain Name
Knowing the strain is half the battle. The other half is finding a product that delivers them alive and in a way that lets them work. Here’s what I learned to look for, often the hard way.
1. The Strain Combination
Look for a product that includes at least one of the S. salivarius strains (K12 or M18) as a primary ingredient. A combination of K12 and M18 is considered a gold standard by many experts. Support from Lactobacillus strains or Weissella cibaria is a big plus. Avoid products that just say "probiotic blend" without listing the specific strains and their designations (like K12). That's a red flag.
2. Colony Forming Units (CFUs)
This is the number of live bacteria. For oral probiotics, you don't necessarily need the astronomically high counts advertised for gut probiotics (like 100 billion). A range between 1 billion to 6 billion CFUs per dose is typical and effective for oral strains. More isn't always better if the strains aren't right or if they're dead on arrival.
3. Delivery Technology
How do you get the bacteria to your mouth? Lozenges, chewable tablets, or fast-dissolving strips are ideal. They allow the bacteria to coat the oral surfaces directly. Capsules you swallow with water are designed for the gut, not the mouth. They're useless for targeting halitosis specifically. I made that mistake with my first purchase—total waste of money.
4. Prebiotics
Some advanced formulas include prebiotics (like xylitol or inulin). These are food for the good bacteria, helping them establish themselves. Xylitol has the added benefit of inhibiting cavity-causing bacteria. It's a nice synergistic touch.
5. Sugar and Additives
Check the label! Avoid products with added sugar, sucrose, or glucose. You're trying to starve the bad bacteria, not feed them. Artificial sweeteners are fine, but natural ones like xylitol or stevia are preferable.
My Personal Checklist: When I shop now, I look for: 1) S. salivarius K12/M18 on the label, 2) a lozenge/chewable form, 3) at least 1-2 billion CFUs per dose, 4) no sugar, and 5) a reputable brand that lists strain designations. It narrows the field down from dozens to maybe two or three good options.
How to Use Oral Probiotics for Maximum Effect
You've got the right bottle. Now what? Timing and technique matter more than you think.
When to take it: The best time is at night, right before bed. Saliva flow decreases while you sleep, giving odor-causing bacteria a party zone. Taking a probiotic lozenge lets the good bacteria work their magic during this critical period. A second dose in the morning can help reinforce the colony.
How to take it: Don't just crunch and swallow. Let the lozenge or tablet dissolve slowly in your mouth. Swish the remnants around a bit to coat your tongue, cheeks, and gums. The goal is maximum contact time.
What to avoid: Don't eat or drink for at least 15-20 minutes after taking it. Definitely don't follow it with an antibacterial mouthwash—you'll just kill all the good bacteria you just paid for. If you use mouthwash, do it at a completely different time of day.
Consistency is key. This isn't an instant fix like a breath spray. It takes days to weeks for the beneficial strains to establish themselves and shift the ecosystem. Give it at least a 4-6 week committed trial before deciding if it works for you.
Common Questions (The Stuff You're Really Wondering)
The Bigger Picture: Probiotics Are One Tool, Not the Whole Toolkit
I wish I could tell you that finding the best probiotic strain for halitosis is the only thing you need to do. But that would be dishonest. Probiotics work best as part of a solid oral hygiene routine.
You still need to brush twice a day and floss. Pay special attention to cleaning your tongue—either with a toothbrush or a dedicated tongue scraper. That's where a huge amount of the odor-producing bacteria live. Stay hydrated; a dry mouth is a smelly mouth. Watch your diet—excessive coffee, alcohol, and strong-smelling foods (garlic, onions) will still cause temporary breath issues no matter how good your probiotics are.
Think of probiotics as the long-term, foundational strategy. They're the good tenants you move into the apartment. Brushing, flossing, and scraping are the daily cleaning and maintenance that keep the whole building from falling apart.
Quick Recap & Final Answer: So, what probiotic strain is best for halitosis? The research points strongly to Streptococcus salivarius K12 and M18 as the most effective, targeted strains. Look for them in a lozenge or chewable form. Support from strains like Lactobacillus reuteri or Weissella cibaria can be beneficial. Remember, this is a marathon, not a sprint. Combine your probiotic with good oral hygiene for the best shot at lasting, fresh breath. It's a more thoughtful approach, but in my experience, it's the one that actually works.
It beats another pack of mints, anyway.